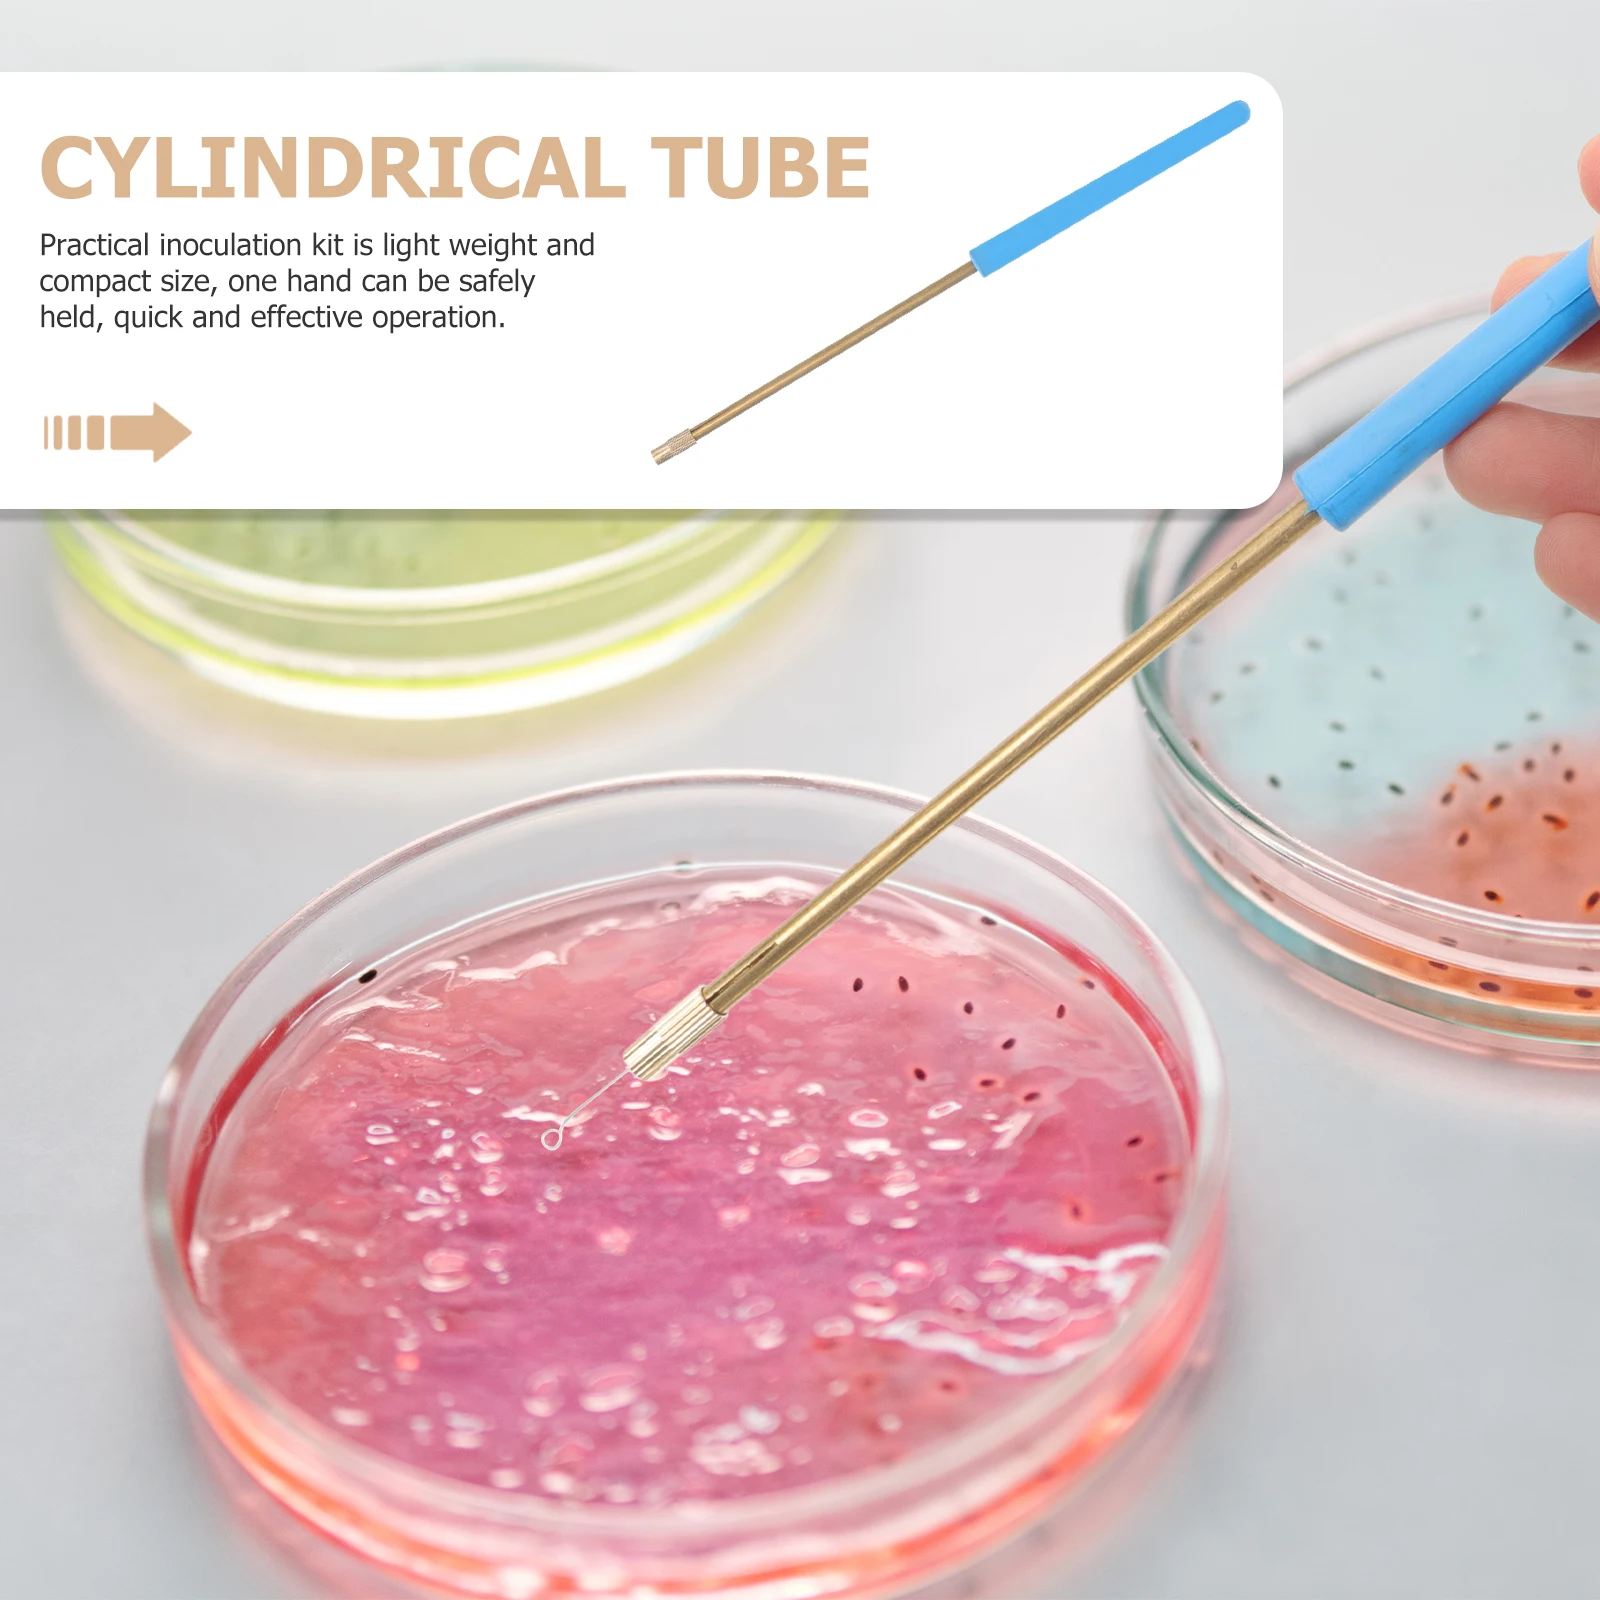
thumb

Loop Kit Inoculating Rod Tool Inoculation Laboratory Tools Microbiology Rods Suite Rings Device
Price history chart & currency exchange rate
Customers also viewed

$45.91
Воспламенитель CDI для NR200/Toyan, модель двухцилиндрового бензинового двигателя
aliexpress.ru
$8.62
Выпрямительный регулятор усилителя Assy 6H2-81960-00 для подвесного мотора Yamaha 2-тактный лодочный мотор 40-70 л.с. 6H2-81960
aliexpress.ru
$44.66
Новый мужской деловой Модный вязаный пуловер из чистой шерсти | Рубашка поло с лацканами | Классический однотонный пуловер | Вязаный свитер для гольфа
aliexpress.ru
$10.63
Outdoor Phone Bag Genuine Bag Bag Luxury Waterproof Sports Mobile Waist One Belt Wearing Men's Small Shoulder Leather 2022 Bag
aliexpress.com
$10.19
SQU OF80 OF 80 SQU OF68 OF 68 Универсальный Эмулятор Immo для автомобиля, мини-детали, большие работы, 42 IMMO программы, 18 мест, TACHO иммобилайзер
aliexpress.ru
$260.42
10-дюймовый L-образный Android 9.0 rk3399 POE планшетный ПК NFC 9,0 часов работы AIO для интеллектуальной системы
aliexpress.ru
$5.00
DC 12V Submersible Water Pump Camper Motorhome High Flow Whale Pump 900L/H 5M High Quality Durable Engineering Plastics Pump
aliexpress.com
$18.90
2021 Summer Women Holiday Casual Off Shoulder Jumpsuits Fashion Ladies Color Striped Bodysuit Wide Leg Loose Long Pants Trousers
aliexpress.com
$22.72
Women's Skirt Suits Fashion Square Neck Floral Lantern Long Sleeve Top And Ruffles Mini Skirt Two Piece Set Women Set Outfit
aliexpress.com
$10.63
Self-swimming Baby Cartoon Animal Swimming Ring Seat Environmental Protection pool accessories круг для плавания
aliexpress.com
$16.33
relogio feminino watches quartz watch ladies watch silicone band luminous calendar watch student trend fashion watch female
aliexpress.com
$15.11
Zen Garden Sand Meditation Peaceful Relax Decoration Set Spiritual Buddha Paper Crane Sand Tray Micro Landscape Feng Shui Yoga
aliexpress.com
$2.76
1Ft 0.5m USB 3.0 Type A Male to Female Extension Extender Cable Cord Adapter Black Extender Wire Cord Fit For PC Notebook
aliexpress.com
$41.92
2020under armour1 mens brand logo hoodies hip hop sweatshirt casual male winter jumper men's hoodies & sweatshirts #9a85, Black
dhgate.com
$45.33
симпатичные мышь и кошка копилка с музыкой new электронные копилка монеты saving boxs стол игрушка для детей день рождения рождество подари
dhgate.com
$31.35
с длинными рукавами ажурные кружева бич sexy v-образным вырезом солнцезащитный perspective рубашки, White
dhgate.com
$0.02
in stock fats ship 3-12 year kids mask cotton boy girl face masks 3-layer washable dustproof earloop mask 202005174
dhgate.com